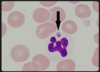
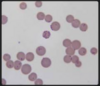

Most common Aspergillus spp. causing SNA in dogs?
A. fumigatus
Most common Aspergillus spp. causing disseminated aspergillosis in dogs?
A. terreus or A. deflectus
% of dogs in which SNA requires trephination/sinus assessmen to allow for diagnosis?
17%
Methods of detecting fngal hyphae in SNA and success rate of these methods?
Nasal dishcarge/swabs: 13 - 20% cases
Brushing/Squash preparations of plaques: 93 - 100%
Sites for fungal culture and sensitivity for diagnosis of SNA
Fungal plaques: 88%
Mucosa: 75%
Nasal swabs: 19%
Best serological test for aspergilluis and its sensitivity and specificty
ELISA (rather than AGID)
Sensitivity 88.2% and specificity 96.8%
What property of topical antifnugals should be considerd wen treating SNA?
Use a PEG based solution as these have less severe local ide effects
What advantage does enilconazole have over clotrimazole for the treatment of SNA?
It is less toxic and is active in a vapour phase up to 1cm distances
What is the reccomended mode of treatment in canine SNA?
Endoscopic debridement of the nasal cavities, follwed by 1hinfusion of 1% clotrimazole cream through blindly placed catheters into the nasalcavities/sinus.
Although this is just the ettinger discussion as other methods have similar results
What is the best way of determining therapeutic efficacy following SNA treatment?
a) CT re-evaluation
b) Monitoring of ELISA
c) Repeat culture
d) Repeat endoscopic re-evaluation
Technicaly d perfomed within 1 month of treatment
Overally first treatment success, number of treatments and overall success rate for SNA
60%, 2 treatments, 92%
What option may be considered for very difficult to treat SNA cases?
Oral antifungals
Surgical debridement
What percentage of dogs wwith SNA may have persistet URT signs after treatment?
≥52%
Which beed is predispsed to diseminated aspergillosis?
GSD
What Csx are reported for canine systemic aspergillosis
Spinal pain +/- paraparesis, bone pain, anorexia, weight loss, lethargy, muscle wasting and fever. Pulmonary and ocular involvemet are possible.
What is the diagnostic standard for disseminated canine aspergillosis?
Culture of organism and visualisation of hyphae

Treatment options for pneuocystosis (4 in order of efficacy/preference)
TMPS
Pentamidine isethionate
Atovaqoune
Clindamycin combined with primaquine
Consider anti-inflammatory doses of corticosteroids in severely affected dogs
What are the characteristics of mycobacterial infections:
a) aerobic vs. anaerobic
b) Gram staining
c) Acid fastness
Aerobic gram positive acid-fast organsism.
What are the main organisms in the canine and feline mycobacterium complexes?

What are the main reservoirs of the following mycobacteria:
a) M. tuberculosis
b) M. bovis
c) M. microti
a) humans
b) cattle
c) Field voles
What are the main routes of infection of mycobacteria?
Skin gastrointestinal and respiratory tracts
Methods of diagnosis of mycobacterial infections
Histopathology with demonstration of acid-fast organisms
Culture (takes 4 - 6 weeks)
PCR possible
Treatment of mycobacteria
- Excision and debridement of cutaneous lesions
- 2 months with rifampicin AND a fluroquinolone or macrolide (ideally pradofloxacin or moxifloxacin) AND clarithromycin/erythromycin
- Addtional 4 - 6 months of rifampicin and either fluroquinolone or macrolide
What is the epidemiologic difference between saprophytic and tuberculoid mycobacterium?
Saprophytic organisms live in the soil and are categorised as slow growing (e.g. M avium) and fast growing.